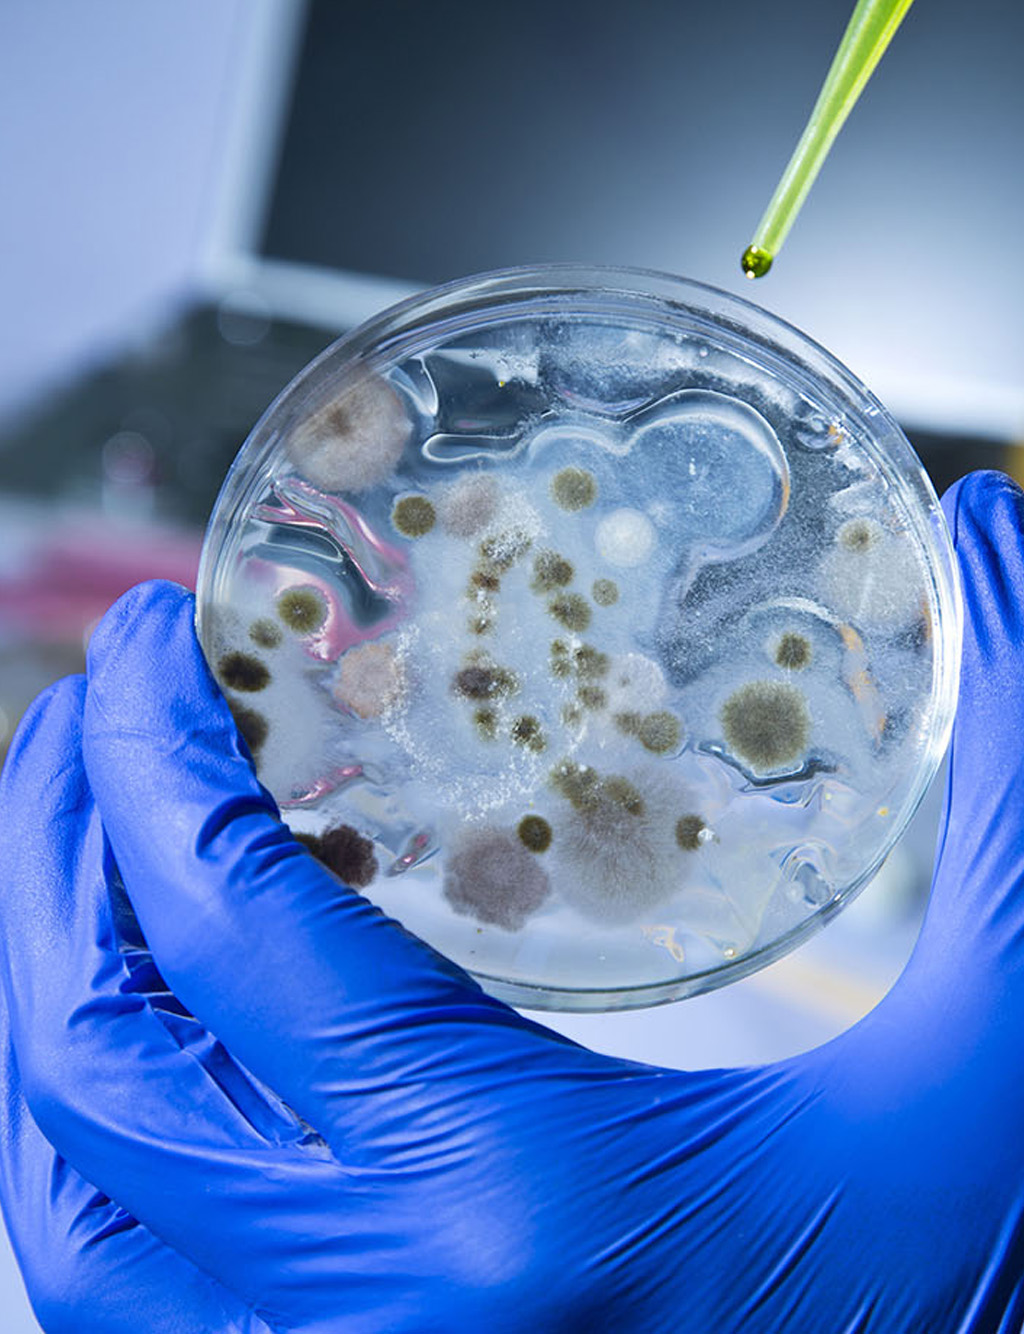

Για να παρέχουμε την καλύτερη εμπειρία, χρησιμοποιούμε τεχνολογίες όπως cookies για την αποθήκευση ή/και την πρόσβαση σε πληροφορίες συσκευών. Η συγκατάθεση για τις εν λόγω τεχνολογίες θα μας επιτρέψει να επεξεργαστούμε δεδομένα προσωπικού χαρακτήρα, όπως συμπεριφορά περιήγησης ή μοναδικά αναγνωριστικά σε αυτόν τον ιστότοπο. Η μη συγκατάθεση ή η ανάκληση της συγκατάθεσης, μπορεί να επηρεάσει αρνητικά ορισμένες λειτουργίες και δυνατότητες.
Η τεχνική αποθήκευση ή πρόσβαση είναι απολύτως απαραίτητη για τον νόμιμο σκοπό της δυνατότητας χρήσης συγκεκριμένης υπηρεσίας που ζητείται ρητά από τον συνδρομητή ή τον χρήστη ή με αποκλειστικό σκοπό τη μετάδοση επικοινωνίας μέσω δικτύου ηλεκτρονικών επικοινωνιών.
Η τεχνική αποθήκευση ή πρόσβαση είναι απαραίτητη για τον νόμιμο σκοπό της αποθήκευσης προτιμήσεων που δεν ζητούνται από τον συνδρομητή ή τον χρήστη.
Η τεχνική αποθήκευση ή πρόσβαση που χρησιμοποιείται αποκλειστικά για στατιστικούς σκοπούς.
Η τεχνική αποθήκευση ή πρόσβαση που χρησιμοποιείται αποκλειστικά για ανώνυμους στατιστικούς σκοπούς. Χωρίς κλήτευση, η εθελοντική συμμόρφωση εκ μέρους του Παρόχου Υπηρεσιών Διαδικτύου ή πρόσθετες καταγραφές από τρίτο μέρος, οι πληροφορίες που αποθηκεύονται ή ανακτώνται για το σκοπό αυτό από μόνες τους δεν μπορούν συνήθως να χρησιμοποιηθούν για την αναγνώρισή σας.
Η τεχνική αποθήκευση ή πρόσβαση απαιτείται για τη δημιουργία προφίλ χρηστών, για την αποστολή διαφημίσεων ή για την καταγραφή του χρήστη σε έναν ιστότοπο ή σε διάφορους ιστότοπους για παρόμοιους σκοπούς εμπορικής προώθησης.